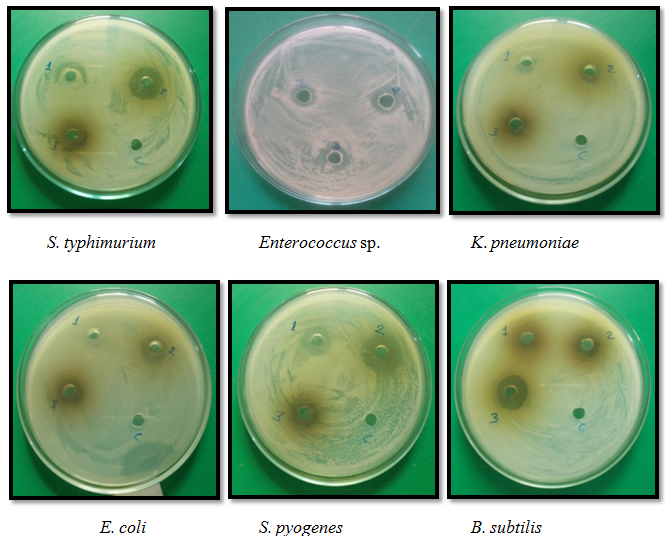

Fungal Biotechnology and Invertebrate Pathology Laboratory, Department of Biological Sciences, Rani Durgavati University, Jabalpur 482001, Madhya Pradesh, India
Email: ssandhu@rediffmail.com
Received: 30 Oct 2015 Revised and Accepted: 09 Sep 2016
ABSTRACT
Objective: The aim of the present study was to isolate the endophytic fungi from medicinal plant Rauvolfia serpentina (L.) Benth. ex Kurz. (Family Apocynaceae) and observed their antibacterial activity against bacteria as well as the molecular characterization of most potent fungal strain.
Methods: Collection and isolation of endophytic fungi from different parts (root, shoot, leaves) of Rauvolfia serpentina plant. Screening of endophytic fungi for antibacterial activity was scrutinised against six bacteria viz. Bacillus subtilis, Enterococcus sp., Klebsiella pneumoniae, Escherichia coli, Salmonella typhimurium and Streptococcus pyogenes by using Agar well diffusion method. For molecular sequencing of potent fungi, the DNA was extracted, quantified and amplified by using two oligonucleotide primers ITS4 and ITS6 in PCR.
Results: A total seven endophytic fungi Aspergillus niger, Penicillium citrinum, Cladosporium sp., Curvularia lunata, Aspergillus sp., Alternaria sp. and Aspergillus fumigatus were isolated from different parts of Rauvolfia serpentina and fungal strain Penicillium citrinum was shown the maximum zone of inhibition against Bacillus subtilis (23.0±0.12 mm), Escherichia coli (19.9±0.16 mm), Streptococcus pyrogens (19.2±0.59 mm), Enterococcus sp., (17.2±0.08 mm), Klebsiella pneumoniae (18.9±0.16 mm) and Salmonella typhimurium (15.1±0.16 mm). The molecular sequencing of the potent fungi was done by primers (ITS4 and ITS6) which showed strong specificity with fungal DNA and the percentages of identical matches of ITS4 and ITS6 DNA sequences in the GeneBank database (NCBI) were determined to 98 %.
Conclusion: In the present study, the endophytic fungal strain Penicillium citrinum showed the potential source of antibacterial bioactive compounds and molecular sequencing of this fungus helps in future to determine the various metabolic pathways that are responsible for the production of such type of novel compounds.
Keywords: Antibacterial activity, Colonization Frequency, Bioactive Compounds, Hyphae, Reserpine
© 2016 The Authors. Published by Innovare Academic Sciences Pvt Ltd. This is an open access article under the CC BY license (http://creativecommons. org/licenses/by/4. 0/)
DOI: http://dx.doi.org/10.22159/ijpps.2016v8i11.9733
INTRODUCTION
Endophytic fungi are the most important part of biodiversity and beneficial for the survival of other organisms. Endophytes play an essential role in ecological processes that includes mutualism, parasitism and commensalism [1-3]. These are symbiotic microorganisms, which live internal tissue of the plant body without causing any negative effects in the host plants [4]. The reproductions in endophytic fungi take place by spores and vegetative growth showing the formation of conidia and hyphae [5]. These are found in different parts of host plant like leaves, petioles, stem, twigs, bark, root, fruit, flower and seeds [1]. Generally, endophytic fungi are classified into different classes based on their host range, colonisation in plants and type of tissue colonised, diversity of plants, transmission and fitness benefits [6]. Endophytic fungi are produced a number of active novel bioactive compounds like alkaloids, peptides, steroids, terpenoids, phenols, quinines and flavonoids which are beneficial in agriculture, industries and in pharmaceutical industries for the production of medicine, drugs and natural biochemical’s those provide protection against pathogenic organisms [7, 8].
Sandhu et al. [9] isolated the endophytic fungi from Calotropis procera (Linn.) R. Br. plant of Jabalpur region and tested their antibacterial activity against Escherichia coli, Klebsiella pneumoniae, Streptococcus pyogenes, Salmonella typhi, Bacillus subtilis and Enterococcus sp. The endophytic fungi Trametes hirsute produce podophyllotoxin and other related aryl tetralin lignans bioactive compounds which used against cancer [10]. In other research work Sandhu et al. [11] also isolated the endophytic fungi Aspergillus fumigatus, Aspergillus niger, Fusarium solani, Aspergillus repens, Alternaria alternata, Alternaria sp., Phoma hedericola and Fusarium oxysporum from Menthe viridis and observed their antibacterial activity against the test bacterial strain and also optimized various parameters for maximum production of antibacterial bioactive compounds.
In the present work endophytic fungi were isolated from the medicinal plant Rauvolfia serpentina also known as Sarpagandha. It is perennial woody rootstock plant commonly found all over the Indian subcontinent and South East Asian countries. More than 80 types of alkaloids are isolated from Rauvolfia species like reserpine [12]. The bioactive compounds isolated from Rauvolfia serpentina used in a number of treatments like insomnia, hypotonic, sedative, sexual aggression, anti-hypertensive and in cardiovascular diseases. Therefore, the present study was to isolated, identified and screening of antibacterial activity of endophytic fungi isolated from different parts of Rauvolfia serpentina.
MATERIALS AND METHODS
Collection of plant sample
Different parts of medicinal plant Rauvolfia serpentina (L.) Benth. ex Kurz. (root, stem and leaves) were chosen for isolation of endophytic fungi. The sample was collected from plant nursery of Jawaharlal Nehru Krishi Vishwa Vidyalaya (JNKVV) Jabalpur (M. P.). The research work was conducted during February to March 2015.
Isolation of endophytic fungi
Isolation of endophytic fungi was carried out by methods described by Petrini [13] with some modification. The plant material was rinsed gently in tap water to remove dust and debris. Then the plant samples were cut into small fragments. Each sample was surface disinfection with 70% ethanol for 1 min and immersed in sodium hypochlorite (NaOCl) for 30 s and then rinsed in sterile distilled water for 1 min. The sample pieces were blotted on dry sterilized Whatman filter paper no. 1. After proper drying, 4 segments of plant sample were transferred on PDA plate which supplemented with an antibiotic (Amoxicillin). Plates were incubated at 26±1 °C for 6 to 7 d. Pure colonies of endophytic fungi appearing from the edge of the segments were transferred to PDA slants and preserved at 4 °C for further study.
Calculation of colonising frequency
Colonization frequency (CF%) was calculated as described by Suryanarayanan et al. [14] and Photita et al. [15]. Colonization frequency (%) of an endophyte species was equal to the number of segments colonised by a single endophyte divided by the total number of segments observed x 100.
Morphological and molecular identification of isolated fungal strain
Morphological identification
Endophytic fungi isolated from R. serpentina were identified by using slide culture technique [16]. Morphological identification of endophytic fungi was done on the basis of their macroscopic and microscopic features such as colour, shape and growth of cultured colonies and the generated data was compared with available literature.
Molecular identification of potential fungi
Isolation of DNA
According to Sandhu, [17] total genomic DNA from the fungi was isolated by LETS buffer (Lithium chloride-EDTA-Tris HCl and Sodium dodecyl sulphate). A conical flask with 50 ml PDB media was inoculated with a loop full of conidia and incubated for 6 to 7 d. Then the mycelia was harvested, washed with distilled water and hand pressed for removal of excess water from the mycelia, dried with filter papers and treated with liquid nitrogen, further crushed in a pastel-motor by adding 0.7 ml LETS {LETS (0.1 M LiCl, 10 Mm EDTA, 10 Mm HCl and pH 8) and 0.5% SDS} extraction buffer. The crushed mycelia were poured in the centrifuge tubes and vortexed for few min and centrifuged at 5000 rpm for 10 min. After centrifugation, the supernatant was transferred into another sterilised tube, and the pellet was discarded. One ml of phenol: chloroform: isoamyl alcohol (25:24:1) was administered in the tubes and vortexed for 1 min at medium speed. It was centrifuged at 10000 rpm in a centrifuge for 10 min. Two distinct layers were formed in the centrifuge tube one aqueous layer and another organic phase. The aqueous layer was transferred in other sterilised tube, and 70% chilled absolute ethanol was added to the sample and kept on ice for 15 min. After that, spinned for 15 min in a microcentrifuge at 4 °C at 10000 rpm for 10 min. The supernatant was removed, and the pellet was dried by inverting the tubes gently and washed with 70% ethanol. The pellet was preserved in nuclease free water for future use.
Quantification and PCR amplification of isolated DNA [18, 19]
The quantity of the isolated DNA was checked in UV-VIS spectrophotometer. From the stock 1 µl, DNA was mixed with 49 µl sterilised distilled water to get 50 times dilution. The A260/280 was recorded to check the purity of DNA. PCR amplification of ITS region was done in 20 μl of reaction mixture containing PCR buffer, 1X (Kappa, SA); MgCl2, 3 mmol; dNTP mix, 0.25 mmol; Taq DNA polymerase, 0.05 U; primer, 1 picomol and template DNA, 50 ng. Sterilised nuclease free water was used as negative control. The oligonucleotide primers used for PCR amplification was ITS4 and ITS6 as depicted in table 1. Thirty-five cycles of PCR were performed by using denaturation at 94 °C for 10 s annealing at 48 °C for 30 s, followed by extension72 °C for 6 min.
Table 1: Primers used for PCR amplification
| Oligonucleotide | Sequences (5’-3’) | GC % | Tm Value | Length | Product size |
| ITS 4 | TCC TCC GCT TAT TGA TAT G | 50 | 51.0 °C | 19 | 700 bp |
| ITS 6 | GAA GGT GAA GTC GTA ACA AGG | 60 | 56.0 °C | 21 |
Source of bacteria strain
The six pathogenic bacteria strain Bacillus subtillis, Streptococcus pyogenes, Escherichia coli, Klebsiella pneumoniae, Salmonella typhimurium and Enterococcus sp. was provided by the Fungal Biotechnology and Invertebrate Pathology Laboratory (FBIPL), RDVV, Jabalpur (M. P.). Bacterial cultures were maintained on nutrient agar medium slant (NAM) and incubated at 37 °C for 24 h in the bacterial incubator and stored at 4 °C for preservation.
Mass production of secondary metabolites [20]
For mass production of a secondary metabolite from endophytic fungi, 250 ml of Potato dextrose broth (PDB) was prepared in 500 ml flasks. The medium was autoclaved at 121 °C and after that inoculated with various fungal cultures and incubated at 26±1 °C in the fungal incubator for 7th 14th and 21st days. After respective days of inoculation (7, 14 and 21 d) the crude extract of the culture broth was filtered by using Whatman filter paper no.1 and observed their antibacterial activity against test bacteria.
Screening of endophytic fungi
The antibacterial activity of endophytic fungi was observed by using Agar well diffusion method [21] against six pathogenic bacteria. In this method, 25 µl of bacterial suspension was spread over the nutrient agar medium plates and allowed to diffuse. The well was made aseptically in the plates with the help of cork borer (8 mm in diameter), and 80 µl of metabolites was introduced into the well. Then the plates were incubated in the bacterial incubator at 37 °C for 24 h. Finally, antibacterial activity was resolute by measuring the diameter of zone of inhibition by using Hi-Media Antibiotic zone scale.
RESULTS
Isolation of endophytic fungi
In the present study, seven endophytic fungi were isolated from the different parts (viz. leaf, stem and root) of the R. serpentina collected from plant nursery of Jawaharlal Nehru Krishi Vishwavidyalaya (JNKVV) Jabalpur M. P. (India) as depicted in table 2. A total 32 segments (leaf 16, stem 8 and root 8) of R. serpentina were processed for the isolation of endophytic fungi.
Table 2: List of endophytic fungi isolated from R. serpentina
| Plant part | Name of endophytic fungi | Class |
| Leaf | Aspergillus niger | Eurotiomycetes |
| Leaf | Penicillium citrinum | Eurotiomycetes |
| Leaf | Cladosporium sp. | Dothideomycetes |
| Leaf | Curvularia lunata | Euascomycetes |
| Stem | Aspergillus sp. | Eurotiomycetes |
| Stem | Alternaria sp. | Dothideomycetes |
| Root | Aspergillus fumigatus | Eurotiomycetes |
Table 3: Colonization frequency (%) of isolated endophytic fungi
| Plant parts | Name of endophytic fungi | % frequency of colonization | No. of isolates |
| Leaf | Aspergillus niger | 12.25 % | 2 |
| Leaf | Penicillium citrinum | 6.25 % | 1 |
| Leaf | Cladosporium sp. | 12.50 % | 2 |
| Leaf | Curvularia lunata | 18.75 % | 3 |
| Stem | Aspergillus sp. | 12.50 % | 1 |
| Stem | Alternaria sp. | 25.00 % | 2 |
| Root | Aspergillus fumigatus | 37.50 % | 3 |
Identification of isolated fungi
Morphological identification of endophytic fungi
The fungal isolates were purified on PDA plates and identified on the basis of their morphological criterion that includes colonies on plates, the morphology of spore, hyphae and color. Based on a morphological feature they were identified as Aspergillus niger, Penicillium citrinum, Cladosporium sp., Curvularia lunata, Aspergillus sp., Alternaria sp. and Aspergillus fumigatus as shown in table 3.
Molecular identification of potent fungi
For the molecular identification both the designed oligonucleotide primers ITS4 (TCC TCC GCT TAT TGA TAT G) and ITS6 (GAA GGT GAA GTC GTA ACA AGG) show strong specificity for fungal DNA sequences. Using BLAST (NCBI), the percentages of identical matches of ITS4 and ITS6 DNA sequences in the Gene Bank database (NCBI) were determined to 98%. This result was obtained by giving denaturation 94 °C for 30 s, annealing 48 °C for 30 s and final extension for processing of DNA amplification was given 72 °C for 6 min. The molecular sequence of Penicilium citrinum is:
CGGGACGGCAGCGGTAAATACTGCGGAGACATTACCGAGTGCGGGCCCCTCGGGGCCCAACCTCCCACCCGTGTTGCCCGAACCTATGTTGCCTCGGCGGGCCCCGCGCCCGCCGACGGCCCCCCTGAACGCTGTCTGAAGTTGCAGTCTGAGACCTATAACGAAATTAGTTAAAACTTTCAACAACGGATCTCTTGGTTCCGGCATCGATGAAGAACGCAGCGAAATGCGATAACTAATGTGAATTGCAGAATTCAGTGAATCATCGAGTCTTTGAACGCACATTGCGCCCTCTGGTATTCCGGAGGGCATGCCTGTCCGAGCGTCATTGCTGCCCTCAAGCCCGGCTTGTGTGTTGGGCCCCGTCCCCCCCGCCGGGGGGACGGGCCCGAAAGGCAGCGGCGGCACCGCGTCCGGTCCTCAAGCGTATGGGGCTTCGTCACCCGCTATAGTAGGCCCGGCCGGCGACAGCCGACCCCCAACCTTTAATTATCTCAAGTTGACCTCAGATCAGGTAGGAATAACCGCC

Fig. 1: 1% Agarose gel data showing the band of amplified DNA (700bp)
Detection of antibacterial activity
To detect the antibacterial activity of metabolites extracted from the endophytic fungi were examined after 7th, 14th and 21st days by Agar well diffusion method against six pathogenic bacteria. The antibacterial assay was carried out in triplicates. From the isolated endophytic fungal strain Penicillium citrinum was showed maximum zone of inhibition against B. subtilis (23.0±0.12 mm), E. coli (19.9±0.16 mm), S. pyogenes (19.2±0.59 mm), Enterococcus sp. (17.2±0.08 mm), K. pneumoniae (18.9±0.16 mm) and S. typhimurium (15.01±0.16 mm) as well as the positive control (Streptomycin) showed the zone of bacterial inhibition ranging from 15.46±0.15 mm to 21.20±0.59 mm shown in table 4.
Table 4: Antibacterial activity of isolated fungal strain
Name of fungal isolates |
Zone of inhibition (in mm) |
|||||
E. coli |
B. subtilis |
Enterococcus sp. |
S. pyogenes |
K. pneumonaie |
S. typhimurium |
|
F. sp. |
- |
- |
- |
12.0±0.10 |
13.1±0.30 |
- |
A. sp. |
05.0±0.12 |
- |
18.0±0.2 |
15.1±0.25 |
17.3±0.36 |
16.0±0.20 |
C. sp. |
14.0±0.21 |
10.9±0.20 |
- |
- |
14.0±0.12 |
- |
C. lunata |
- |
14.4±0.46 |
- |
- |
14.9±0.16 |
16.1±0.16 |
Asp. sp. |
- |
- |
- |
- |
- |
- |
P. citrinum |
19.9±0.16 |
23.0±0.12 |
17.2±0.08 |
17.2±0.15 |
18.9±0.16 |
15.1±0.16 |
N. sp. |
- |
- |
- |
- |
05.0±0.12 |
- |
Streptomycin (1 mg/ml) |
16.1±0.11 |
19.2±0.10 |
15.4±0.15 |
21.2±0.59 |
17.4±0.10 |
18.4±0.58 |
*Each value in the table is represented as mean±SD (n = 3). F. sp.: Fusarium sp., A. sp.: Alternaria sp., C. sp.: Cladosporium sp., C. lunata: Curvularia lunata; Asp. sp.: Aspergillus sp., P. citrinum: Penicillium citrinum and N. sp.: Nigrospora sp.
Broad-spectrum activity of endophytic fungi
For the broad-spectrum activity of endophytic fungi against 6 pathogenic bacterial strains are shown in table 5 and fig. 2. Penicillium citrinum showed a maximum zone of inhibition against E. coli (19.2±0.30 mm), B. subtilis (23.0±0.10 mm), Enterococcus sp. (17.3±0.20 mm), S. pyogenes (19.3±0.15 mm), K. pneumonaie (18.4±0.32 mm) and S. typhimurium (15.6±0.45 mm). Similarly, Alternaria sp. was also showed a zone of inhibition against Enterococcus sp. (18.2±0.25 mm), S. pyogenes (15.1±0.25 mm), K. pneumoniae (17.6±0.58 mm), S. typhimurium and (16.8±0.80 mm), E. coli (05.7±00.43 mm). In the case of Curvularia lunata it showed antibacterial activity against B. subtilis (13.5±0.30 mm), K. pneumoniae (15.7±1.07 mm) and S. typhimurium (16.7±0.32 mm).
Table 5: Broad-spectrum activity of selected endophytic fungi
Endophytic fungi |
Zone of inhibition (in mm) |
|||||
E. coli |
B. subtilis |
Enterococcus sp. |
S. pyogenes |
K. pneumoniae |
S. typhimurium |
|
Alternaria sp. |
05.7±0.43 |
- |
18.2±0.25 |
15.1±0.40 |
17.6±0.58 |
16.8±0.80 |
Curvularia lunata |
- |
13.5±0.30 |
- |
- |
15.7±1.07 |
16.7±0.32 |
Penicillium citrinum |
19.02±0.30 |
23.0±0.10 |
17.3±0.20 |
19.3±0.15 |
18.4±0.32 |
15.6±0.45 |
*Each value in the table is represented as mean±SD (n=3).
Fig. 2: Antibacterial activities in endophytic fungi
DISCUSSION
The seclusion of endophytic fungi from medicinal plant produces a number of bioactive compounds, which have a therapeutic value. Therefore, in the present work endophytic fungi were isolated from the medicinal plant R. serpentina and observed their antibacterial against six pathogenic bacteria. The endophytic isolated Penicilium citrinum was displayed the best result against all the test strains. Similar, result was observed by Sandhu et al. [20] isolated the endophytic fungi from Saraca indica and detect their antibacterial activity against pathogenic bacteria and pointed to these endophytic fungi have the capability to produce a number of antibacterial bioactive compounds of multiple uses. Shekhawat et al. [22] were also isolated 35 endophytic fungi from leaves, the root of Melia azadirichta L. and observed their antibacterial activity against test strains. The endophytic fungi Aspergillus fumigatus, Aspergillus japonicas, Aspergillus niger, Fusarium semitectum, Curvularia pallescens, Phoma hedericola, Alternaria tenuissima, Fusarium solani, Drechslera australien and Aspergillus repens isolated from the medicinal plant Ricinus communis (L.) plant and observe their antibacterial activity against pathogenic bacteria [23]. Previous research worker had examined the production of the anti-leukemic and anti-tumor drug taxol from the endophytic fungi like Taxomyces andreanae and Pestalotiopsis microspora of Taxus spp. [24, 25].
The molecular identification of Penicillium citrinum was also done by using oligonucleotide primer for easy identification and comparison of molecular characteristics of the fungi with other organisms. Silva et al. [26] also identified the different strain of Aspergillus species on the basis of their morphological as well as molecular characteristics. Nyongesa et al. [27] isolated the Aspergillus species from the maize kernel and soil of maize field of Nandi County and identified on the basis of macroscopic and microscopic morphological characteristics.
ACKNOWLEDGEMENT
The authors wish to thank the Vice Chancellor of R. D. University, Jabalpur, India and the Head of the Department of Biological Science, R. D. University Prof. Y. K. Bansal for providing laboratory facility for this project.
CONFLICT OF INTERESTS
The authors have no potential conflict of interest regarding publication of the said manuscript.
REFERENCES
How to cite this article